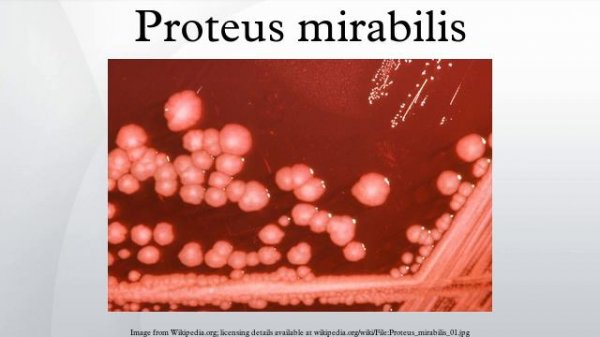
Proteus mirabilis

Найдено результатов: 100
Mirabilis

MONTAGEM ASTRA MIRABILIS - DJ MH

Montagem Astra mirabilis (Super Slowed + reverb)

Cercestis Mirabilis

#мирабилис #ночнаякрасавица / Мирабилис( лат. Mirabilis). Ночная красавица сада

MONTAGEM ASTRA MIRABILIS (Ultra Slowed) 1Hour

How to grow Phyllanthus Mirabilis (caudex plant), a simple bonsai that don't need to bend or prune

Мирабилис ночная красавица. Мирабилис из семян. Мирабилис выращивание

Мирабилис. Как выглядит рассада. Mirabilis.

Мирабилис после прищипки!!!???.Обзор рассады. Mirabilis.

Crazy love by MIRABILIS | Динамичная песня о безумной любви

Прищипка мирабилиса для пышности???. Pinching the mirabilis.???

Proteus mirabilis

Cercestis Mirabilis, cakep Bertato

Каудексное растение Филлантус мирабилис (Phyllanthus Mirabilis)
Proteus mirabilis

Proteus mirabilis

PROTEUS MIRABILIS

mirabilis.Мирабилис ялапа, или Ночная красавица

Чуточку дольше от MIRABILIS

Proteus mirabilis

Непентес Мирабилис (Nepenthes Mirabilis)

Her call by MIRABILIS | Песня в стиле рок-баллады о поиске дома и любви | Музыка для души

Mirabilis - World Indifferent

CERCESTIS MIRABILIS